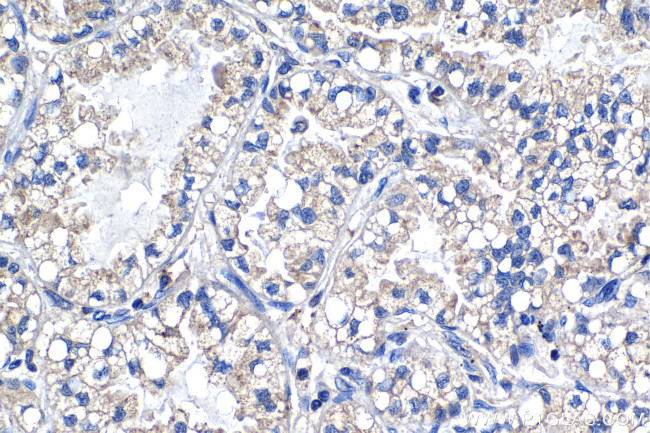
PTP4A1 Antibody in Immunohistochemistry (Paraffin) (IHC (P))

Search
Proteintech
PTP4A1 Monoclonal Antibody (2C9E10)
{{$productOrderCtrl.translations['antibody.pdp.commerceCard.promotion.promotions']}}
{{$productOrderCtrl.translations['antibody.pdp.commerceCard.promotion.viewpromo']}}
{{$productOrderCtrl.translations['antibody.pdp.commerceCard.promotion.promocode']}}: {{promo.promoCode}} {{promo.promoTitle}} {{promo.promoDescription}}. {{$productOrderCtrl.translations['antibody.pdp.commerceCard.promotion.learnmore']}}
产品信息
67584-1-IG
种属反应
宿主/亚型
分类
类型
克隆号
抗原
偶联物
形式
纯化类型
保存液
内含物
保存条件
运输条件
产品详细信息
Immunogen sequence: MARMNRPAPV EVTYKNMRFL ITHNPTNATL NKFIEELKKY GVTTIVRVCE ATYDTTLVEK EGIHVLDWPF DDGAPPSNQI VDDWLSLVKI KFREEPGCCI AVHCVAGLGR APVLVALALI EGGMKYEDAV QFIRQKRRGA FNSKQLLYLE KYRPKMRLRF KDSNGHRNNC CIQ
靶标信息
The protein encoded by this gene belongs to a small class of prenylated protein tyrosine phosphatases (PTPs), which contains a PTP domain and a characteristic C-terminal prenylation motif. PTPs are cell signaling molecules that play regulatory roles in a variety of cellular processes. This tyrosine phosphatase is a nuclear protein, but may primarily associate with plasma membrane. The surface membrane association of this protein depends on its C-terminal prenylation. Overexpression of this gene in mammalian cells conferred a transformed phenotype, which implicated its role in the tumorigenesis. Studies in rat suggested that this gene may be an immediate-early gene in mitogen-stimulated cells. PRL phosphatases increase cell proliferation by stimulating progression from G1 into S phase. PRL-1 function is regulated in a cell cycle-dependent manner and implicate PRL-1 in regulating progression through mitosis, possibly by modulating spindle dynamics.
仅用于科研。不用于诊断过程。未经明确授权不得转售。
篇参考文献 (0)
生物信息学
蛋白别名: DKFZp779M0721; PRL-1; protein tyrosine phosphatase 4a1; Protein tyrosine phosphatase type IVA 1; protein tyrosine phosphatase type IVA protein 1; Protein-tyrosine phosphatase 4a1; Protein-tyrosine phosphatase of regenerating liver 1; PTP(CAAXI); PTP4A1 protein; PTP4A2; RP5-1148A21.2
基因别名: AA415290; AU019864; C130021B01; HH72; PRL-1; PRL1; PTP(CAAX1); PTP4A1; PTPCAAX1
UniProt ID: (Human) Q93096, (Rat) Q78EG7, (Mouse) Q63739
Entrez Gene ID: (Human) 7803, (Rat) 29463, (Mouse) 19243